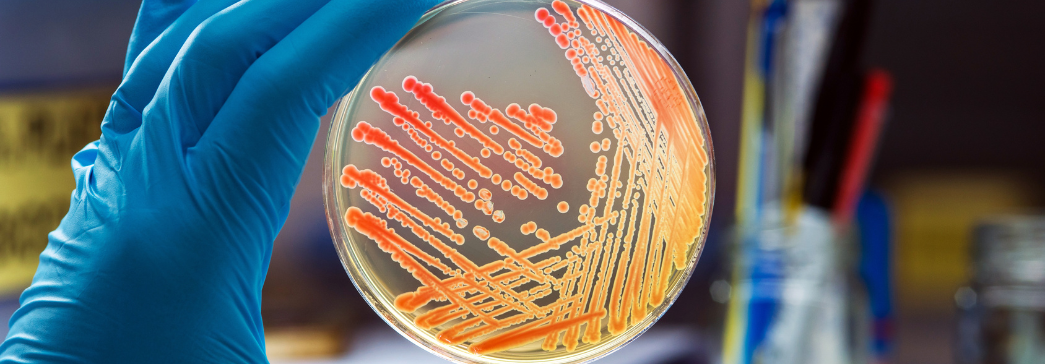
Arte e Cultura

Vitrine tecnológica
Grupo de Pesquisa em Epidemiologia
Saúde e Bem-estar
Descrição do grupo de pesquisa:
atua na produção e aplicação do conhecimento para identificação e controle de problemas de saúde em diferentes populações. Suas pesquisas abrangem qualidade de vida em doenças neuromusculares, epidemiologia aplicada a serviços de saúde, saúde do trabalhador, câncer, envelhecimento, saúde da mulher e estudos de evidência científica por meio de revisão sistemática e metanálise. Conta com um laboratório estruturado e tecnologia especializada para análise de dados e desenvolvimento de pesquisas epidemiológicas.
Líderes:
Maria Inês da Rosa
Linhas de pesquisa:
Avaliação da Qualidade de Vida e Funcionalidade nas Doenças Neuromusculares
Epidemiologia aplicada em Serviços de Saúde
Epidemiologia da Saúde do Trabalhador
Epidemiologia do câncer
Epidemiologia do Envelhecimento
Revisão Sistemática e Metanálise
Saúde da Mulher
CNPQ:
http://dgp.cnpq.br/dgp/espelhogrupo/13761
Contato:
Entre em contato com os responsáveis;
E-mail: mir@unesc.net
Telefone: (48) 3431-2741


